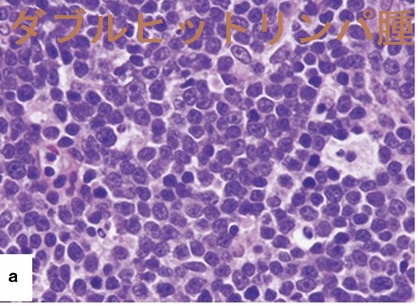

甲状腺と悪性リンパ腫(原発性甲状腺リンパ腫),甲状腺MALTリンパ腫,びまん性大細胞型Bリンパ腫(DLBCL)[橋本病 長崎甲状腺クリニック 大阪]
甲状腺:専門の検査/治療/知見③ 橋本病 バセドウ病 甲状腺エコー 長崎甲状腺クリニック大阪
甲状腺専門の長崎甲状腺クリニック(大阪府大阪市東住吉区)院長が海外・国内論文に眼を通して得た知見、院長自身が大阪市立大学大学院医学研究科(現、大阪公立大学大学院医学研究科) 代謝内分泌病態内科で得た知識・経験・行った研究、甲状腺学会で入手した知見です。
長崎甲状腺クリニック(大阪)以外の写真・図表はPubMed等において学術目的で使用可能なもの(Creative Commons License)、public health目的で官公庁・非営利団体等が公表したものを一部改変しています。引用元に感謝いたします。尚、本ページは長崎甲状腺クリニック(大阪)の経費で非営利的に運営されており、広告収入は一切得ておりません。
甲状腺・動脈硬化・内分泌代謝・糖尿病に御用の方は 甲状腺編 動脈硬化編 甲状腺以外のホルモンの病気(副甲状腺/副腎/下垂体/妊娠・不妊など) 糖尿病編 をクリックください
Summary
橋本病やバセドウ病の甲状腺に発生する甲状腺原発悪性リンパ腫(原発性甲状腺リンパ腫)は、MALTリンパ腫, びまん性大細胞型Bリンパ腫(DLBCL), 両者混合型が3割ずつ。90%は急速に大きくなり、気道閉塞の危険も。IL2-R(可溶性インターロイキン2受容体)が高値になります。甲状腺超音波(エコー)検査(下部閉塞によるリンパ管拡張で網目状の低エコー領域、偽嚢胞石灰化なし)、甲状腺の穿刺細胞診(MALTリンパ腫は診断できない事が大半)・組織生検、ガリウムシンチグラフィーで診断。橋本病リンパ球浸潤、甲状腺未分化癌と鑑別要する。
Keywords
橋本病,バセドウ病,甲状腺,悪性リンパ腫,MALTリンパ腫,びまん性大細胞型Bリンパ腫,sIL2-R,エコー,PET,ガリウムシンチグラフィー
甲状腺原発悪性リンパ腫のほとんどは、非ホジキン型のB-細胞性リンパ腫で、一般のリンパ腫に比べ予後良好です。
甲状腺原発悪性リンパ腫の1/3を占めるで甲状腺MALTリンパ腫(節外性濾胞辺縁帯性リンパ腫)は、最も悪性度が低く、比較的緩やかな増大速度で、甲状腺内に長く留まるため、頚部超音波(エコー)検査、CT/MRI、PETなどで偶然見つかる事が多いです。(Endocr J. 2009; 56(3):399-405.)
甲状腺専門医では、初診時はもちろん、定期的に甲状腺超音波(エコー)検査を行うので、甲状腺MALTリンパ腫の早期発見が可能になります。
早期発見されず、甲状腺MALTリンパ腫が急速に増大すると、窒息等の危険が生じ、外科手術で甲状腺MALTリンパ腫を甲状腺ごと完全に取り切るのが不可能になります。
甲状腺機能低下症/橋本病に対して、ろくに甲状腺超音波(エコー)検査もせずチラーヂンSを漫然と何年も投与していると、甲状腺原発悪性リンパ腫を早期発見する機会を失ってしまいます(橋本病(慢性甲状腺炎)に発生する甲状腺原発悪性リンパ腫)。
ただし、甲状腺MALTリンパ腫は、診断に苦慮する甲状腺腫瘍の1つです(診断が付かない甲状腺MALTリンパ腫)。
悪性度の高い甲状腺原発MALTリンパ腫
例外的に、悪性度が高く、初診時から多発肺転移を認めた甲状腺MALTリンパ腫の症例も報告されています。
関節リウマチ・橋本病が基礎にあって、関節リウマチ自体と治療薬の免疫抑制剤が、腫瘍に対する免疫監視機能を低下させ、本来、悪性度の低い甲状腺MALTリンパ腫を多発肺転移させた可能性が考えられます。(第59回 日本甲状腺学会 P3-4-5 初診時から多発の肺転移を認めた甲状腺原発MALTlymphoma の1 例)
高悪性度MALTリンパ腫の5年生存率は25%であり、びまん性大細胞型Bリンパ腫(DLBCL)の75%と比べ予後不良でした。[Histopathology. 2000 Jul;37(1):10-8.]
びまん性大細胞型Bリンパ腫(DLBCL)は、混合型も含め、甲状腺原発悪性リンパ腫の70%を占めます(Surgery. 2009 Dec; 146(6):1105-15.)。
びまん性大細胞型Bリンパ腫(DLBCL)はMS4A1(CD20)陽性、75%はBCL6癌遺伝子(オンコジーン)陽性、50%でBCL2オ癌遺伝子(オンコジーン)陽性(Ann Oncol. 2007 Jul; 18(7):1203-8.)。
甲状腺原発悪性リンパ腫の中では、最も悪性度の高い組織型で60%が発見時に転移しています。
びまん性大細胞型Bリンパ腫(DLBCL)は、B細胞分化段階の遺伝子発現パ ター ンから
- 胚中心B細胞型Germinal center B-cell-like (GCB) type
- 活性型B細胞型Activated Bcell-like (ABC) type
に分類されます。胚中心B細胞型(GCB type)は、活性型B細胞型(ABC type)に比較して有意に予後が良いです(Nature. 2000 Feb 3;403(6769):503-11.)。
ダブルヒットリンパ腫(double hit lymphoma:DHL)は、びまん性大細胞型B細胞リンパ腫(DLBCL)の一部で、細胞増殖に関わるMYC遺伝子と、細胞死を阻害するBCL2遺伝子の両方に再配列(遺伝子転座)が起きたもの。悪性度が高く、急速に進行して予後不良。びまん性大細胞型B細胞性リンパ腫(DLBCL)で一般的に行われるR -CHOP療法には抵抗性。[Indian J Hematol Blood Transfus. 2014 Sep;30(Suppl 1):166-73.]
ダブルヒットリンパ腫のHE組織像は、びまん性大細胞型B細胞リンパ腫(DLBCL)と同じ。[組織像、Mod Pathol. 2015 Feb;28(2):208-17. ]
甲状腺原発T細胞性悪性リンパ腫は甲状腺原発悪性リンパ腫(原発性甲状腺リンパ腫)の2%と稀です(Histopathology. 1996 Jan; 28(1):25-32.)。
B細胞系と同じく、橋本病を基礎病変として発生し、sIL2-R(可溶性インターロイキン2受容体)が上昇します。免疫染色では、T細胞マーカーの「CD30」が陽性に染まります。報告例が少なく、治療法は確定していませんが、外科摘出の報告が多い。予後も不明ですが、予後不良の(他臓器)末梢性T細胞リンパ腫非特定型(PTCL-NOS)と異なり、予後良好の報告が多い。(Pathol Int. 2005 Jul;55(7):425-30.)(World J Surg Oncol. 2012 Apr 19;10:58.)
末梢性T細胞リンパ腫非特定型(peripheral T-cell lymphoma, not otherwise specified:PTCL- NOS)
末梢性T細胞リンパ腫(peripheral T-cell lymphomas:PTCL)は、胸腺で分化成熟した後、末梢臓器に移動したT細胞リンパ腫です。
末梢性T細胞リンパ腫非特定型(peripheral T-cell lymphoma-not otherwise specified:PTCL-NOS)はリンパ腫全体の約7%を占めます。成人に多く、男女比は2:1と男性に多い。リンパ節、骨髄・肝臓・脾臓の他、皮膚・消化管が多く甲状腺の報告もあります。(Br J Haematol. 2013 Apr;161(2):214-23.)
末梢性T細胞リンパ腫非特定型(PTCL-NOS)の骨髄浸潤は約20%、化学療法抵抗性、5年生存率20〜30%と予後不良。
T細胞受容体遺伝子の再編成は、胸腺内におけるT細胞分化の過程で生じる重要な現象であり、認められれば末梢性T細胞リンパ腫非特定型(PTCL-NOS)の診断根拠になります。
甲状腺の原発性末梢性T細胞リンパ腫は、他臓器のものとは異なり、
- すべてがびまん性甲状腺腫
- すべてが自己免疫性甲状腺炎(甲状腺機能低下症/橋本病)を合併
- 一部は甲状腺生検の後に退縮
- 50%は白血病症状
- すべてがCD3、CD4、CXCR3 陽性(1型ヘルパーT細胞起源)
- 6q24·2の損失は特徴的で約66%に認める
(Br J Haematol. 2013 Apr;161(2):214-23.)
甲状腺末梢性T細胞リンパ腫の超音波(エコー)所見、病理組織所見は甲状腺MALTリンパ腫とほぼ同じ。(Hum Pathol. 2013 Sep;44(9):1927-36.)
非常に珍しいですが、甲状腺原発バーキットリンパ腫の症例も報告されています。(第55回 日本甲状腺学会 P2-05-03 甲状腺悪性リンパ腫(Burkitt-like lymphoma)の稀な一例)(Case Rep Oncol. 2012 May;5(2):388-93.)[BMC Endocr Disord. 2018 Nov 19;18(1):86.]
甲状腺原発バーキットリンパ腫は、急速に進行する予後不良のB細胞系リンパ腫で、
- 急激な頚部腫脹と気管圧排による呼吸困難→気道閉塞・窒息(Case Rep Pediatr. 2014;2014:187467.)
- 破壊性甲状腺炎(第64回 日本甲状腺学会 6-2 破壊性甲状腺中毒症を伴った甲状腺原発バーキットリンパ腫の一例)
- 上顎骨、下顎骨、および副鼻腔周辺の骨破壊を特徴とする[Neuroimaging Clin N Am. 2003 Aug;13(3):371-92.]
を起こします。
バーキットリンパ腫の約30%には、エプスタイン‐バールウイルス (EBV)感染が関与するとされますが[Am J Clin Pathol. 2008 Aug;130(2):186-92.]、甲状腺原発バーキットリンパ腫での関与は否定的との報告があります[Diagn Pathol. 2020 Feb 8;15(1):13.]。
写真;甲状腺原発バーキットリンパ腫 CT画像[Case Rep Pediatr. 2014:2014:187467.]
甲状腺原発バーキットリンパ腫 超音波(エコー)画像;画像所見は他の悪性リンパ腫と同じ[BMC Endocr Disord. 2018 Nov 19;18(1):86.]
バーキットリンパ腫は異型性の強い細胞ですが、穿刺細胞診ではMALTリンパ腫と同様、多数のリンパ球を認めるのみで、コアニードル生検(CNB)で確定診断されるケースがあります[BMC Endocr Disord. 2018 Nov 19;18(1):86.]。
甲状腺原発バーキットリンパ腫 組織像;複数の有形体マクロファージによる星空パターン(starry sky appearance)になります。びまん性大細胞型Bリンパ腫(DLBCL)との鑑別要。
報告では、R-HYPER-CVAD(リツキシマブ、多分割投与のシクロホスファミド、ビンクリスチン、ドキソルビシン、デキサメタゾン)療法を行ったが、好中球減少症のためR-CHOP療法に変更。
甲状腺エコー上は、↑写真のような低エコー領域です(甲状腺MALTリンパ腫)。
- 元々、リンパ球浸潤は低エコーに見えますが、増殖したリンパ腫細胞はエコーを反射しないため極めて低エコーに見えます。[PLoS One. 2014 Dec 4;9(12):e114080.]
- まだら状(虫食い状とも表現されます)で、一見、橋本病の炎症によるのう胞変性(嚢胞変性)の集簇に見えますが、極めて低エコーな部分は内部血流が存在するため偽のう胞(偽嚢胞)。拡大してみると、リンパ節の病理組織のような網目状構造が認められます。下部閉塞によるリンパ管拡張で網目状に見えます。
同時に、拡張したリンパ管そのものも多数認めます。
- 石灰化しないのが特徴。
甲状腺MALTリンパ腫(節外性濾胞辺縁帯性リンパ腫)
ケース①
ケース②
ケース③
ケース④
びまん性大細胞型Bリンパ腫(DLBCL)
びまん性大細胞型Bリンパ腫(DLBCL)超音波(エコー)画像;MALTリンパ腫と比べると、内部がかなり粗雑で、血管浸潤も認める(白矢印)(J Thorac Dis. 2017 Nov;9(11)4774-4784.)
橋本病(慢性甲状腺炎)に発生する甲状腺原発悪性リンパ腫
バセドウ病に発生する悪性リンパ腫(甲状腺原発悪性リンパ腫)
バセドウ病に発生する悪性リンパ腫(甲状腺原発悪性リンパ腫)は見つけにくいが、
- 怪しい低エコー領域を穿刺細胞診して見つかる事があります。(Thyroid. 2004 Sep;14(9):772-6.)
- I-123 シンチグラフィーあるいは99Tcmシンチグラフィーの取り込み(集積)不良な領域(cold spot)から見つかる事があります。また、アイソトープ治療(放射性ヨウ素; I-131 内用療法)後、甲状腺全体は縮小するのに、甲状腺悪性リンパ腫の部位だけ縮小しないため見つかる事があります。(第55回 日本甲状腺学会 P2-05-01 バセドウ病のI-131 内用療法後に診断された甲状腺MALT リンパ腫の1 例)[Acta Chir Belg. 2008 Nov-Dec;108(6):702-7.][Br J Radiol. 1991 Jul;64(763):569-75.]
- 早期発見できず、教科書通りの急激な頚部腫脹で見つかる事もがあります。(J Community Hosp Intern Med Perspect. 2021 Jan 26;11(1):79-80.)
バセドウ病でも79%は抗甲状腺ペルオキシダーゼ抗体(TPO抗体)もしくは抗サイログロブリン抗体(Tg抗体)陽性のため、甲状腺悪性リンパ腫が発生しても不思議はありません(抗サイログロブリン抗体(Tg抗体)・抗甲状腺ペルオキシダーゼ抗体(TPO抗体))。
「甲状腺原発悪性リンパ腫の90%は3か月程で急速に、10%はゆっくり甲状腺が大きくなる」とされます。確かに、橋本病で甲状腺が大きくなってきた時は甲状腺原発悪性リンパ腫の合併を疑い甲状腺超音波(エコー)検査、甲状腺の穿刺細胞診、甲状腺組織生検、ガリウムシンチグラフィーが必要。
また、最大20%で体重減少や寝汗の症状が出ます(Head Neck. 2013 Feb; 35(2):165-71.)。
教科書的には以上の様になっていますが、現実は異なります。甲状腺原発悪性リンパ腫の30%–60%は甲状腺機能正常(Histopathology. 1996 Jan; 28(1):25-32.)。長崎甲状腺クリニック(大阪)で、橋本病(慢性甲状腺炎)破壊の程度を評価 するために、甲状腺超音波(エコー)検査を行うと、急速増大する前の甲状腺悪性リンパ腫が多く見つかります。「90%は3か月程で急速に、10%はゆっくり甲状腺が大きくなる」は、裏を返すと、急速に甲状腺が大きくならない限り、甲状腺超音波(エコー)検査をしない医療機関が多いと言う事です。
さらに、最近は超音波(エコー)診断装置の普及と高性能化により、無症状で早期発見される甲状腺悪性リンパ腫が急増しています。
特に、甲状腺MALTリンパ腫は、限局性に長期間留まるため、甲状腺超音波(エコー)検査、肺・頚椎のCT/MRI、頸動脈エコー検査などで偶発的に発見される場合がほとんどです。
早期発見されず、甲状腺悪性リンパ腫が急速に大きくなると、
- 急激な頚部腫脹(急に首が腫れる)、頚の痛み
- 呼吸困難(息苦しい)
- 嚥下障害(飲み込みにくい)
- 嗄声(声が枯れる)
- 微熱
- 無症状、無痛性のまま
などの症状を呈します(Asian J Surg. 2010 Jan;33(1):20-4.)。そして、気道閉塞をおこす可能性があり、
- 気道閉塞症状が現れたら、速やかに気管内挿管し、ステロイドパルス療法が必要。(Rev Laryngol Otol Rhinol (Bord). 1996;117(3):237-9.)(第58回 日本甲状腺学会 P1-13-6 急速に気道閉塞症状を来たした悪性リンパ腫を合併した橋本病の一例)
- 急速な気道閉塞でなければ、生検後、プレドニゾロン内服を次項の化学療法に先行して行うだけでも、甲状腺悪性リンパ腫が早急に縮小する場合もある。(第57回 日本甲状腺学会 P2-069 ステロイド投与で気流制限が改善した甲状腺悪性リンパ腫の一例)
- 形状記憶合金製の気管ステントによる緊急拡張(Thyroid. 2009 Feb;19(2):193-5.)
などの処置が必要。また、急激に甲状腺悪性リンパ腫が増大する時は、
- 破壊性甲状腺炎(甲状腺中毒症)
- 急速な甲状腺機能低下症(元々、橋本病による甲状腺機能低下症があれば重症化)
になります。
甲状腺悪性リンパ腫を気管支喘息と間違われる場合も
甲状腺悪性リンパ腫を気管支喘息と間違われる場合もあります。甲状腺悪性リンパ腫が急速に大きくなり気道を狭窄すると、気管支喘息のような喘鳴(ヒーヒーした呼吸)がおこります。ストライダー(上気道・中枢気道狭窄による喘鳴)と呼ばれ、気管支喘息ではありませんが、聴診すると笛声音(ヒューヒューする音)が聞こえます。気管支喘息の治療目的でステロイド点滴すると、癌とは言えリンパ球なので甲状腺悪性リンパ腫も抑制されて縮小、気道狭窄が改善されます。気管支喘息と思い込んでしまい、甲状腺悪性リンパ腫が見逃される可能性があります。(Rev Laryngol Otol Rhinol (Bord). 1996;117(3):237-9.)
甲状腺悪性リンパ腫ではsIL2-R(可溶性インターロイキン2受容体)高値[甲状腺機能亢進症、無痛性甲状腺炎でも高値]、LDH高値(国際予後因子)、CRP高値。破壊によるサイログロブリン高値。甲状腺ホルモン値は母体となる甲状腺機能低下症、甲状腺機能亢進症を反映する事が多い。急激に増大すると破壊性甲状腺炎(甲状腺中毒症)→急速な甲状腺機能低下症。細胞密度が高い中心部で穿刺細胞診。細胞像は単一な腫瘍細胞、核はMALTリンパ腫(中型)、びまん性大細胞型Bリンパ腫(DLBCL)(大型)ともにN/C比大。DLBCLは非腫瘍性の小型リンパ球とtwo cell pattern。
甲状腺悪性リンパ腫,sIL2-R,可溶性インターロイキン2受容体,LDH,CRP,穿刺細胞診,核,MALTリンパ腫,びまん性大細胞型Bリンパ腫,DLBCL
悪性リンパ腫ではsIL2-R(可溶性インターロイキン2受容体)が産生され高値になります。
- sIL2-Rは甲状腺機能亢進症/バセドウ病、無痛性甲状腺炎でも、甲状腺ホルモンがリンパ球を刺激する事により高値を示します。[Clin Endocrinol (Oxf). 1992 Nov;37(5):415-22.][J Clin Pharm Ther. 2004 Apr;29(2):151-6.](第55回 日本甲状腺学会 P1-03-11 可溶性インターロイキン2受容体(IL2-R)異常高値を示した肝不全、DIC合併の甲状腺クリーゼ(TS)の1例)
- 実際の所、甲状腺悪性リンパ腫(MALT)は、病勢の弱いものが多く、sIL2-Rはリンパ腫の大きさの割に低い(と言うより正常の)症例が多いです。
甲状腺悪性リンパ腫(DLBCL)で広範囲に浸潤、リンパ節転移までしたものは著明に上昇します。
- sIL2-Rは成人T細胞白血病/リンパ腫、リンパ性白血病、サルコイドーシス/膠原病、結核・肝炎/伝染性単核球症などのウイルス感染症、ワクチン接種後、血球貪食症候群、肺癌など悪性腫瘍でも上昇します。
- 甲状腺分化癌(乳頭癌・濾胞癌);頸部リンパ節転移、遠隔転移した場合、甲状腺機能低下状態であっても高値になる。[J Endocrinol Invest. 1994 Dec;17(11):861-7.]
また、LDH(乳酸脱水素酵素)は、悪性リンパ腫の国際予後因子です。しかしながら、甲状腺原発MALTリンパ腫は、病勢の弱いものが多く、LDHはリンパ腫の大きさに比して低い(と言うより正常の)症例が多いです。
LDHは甲状腺機能低下症そのものでも上昇しますが、LDHアイソザイムは骨格筋由来[CK (CPK、クレアチニンキナーゼ)と連動]です。[J Am Geriatr Soc. 1977 May;25(5):199-201.]
炎症や悪性腫瘍で上昇するCRP(C反応性蛋白)。甲状腺原発悪性リンパ腫でも上昇する事があります。
β2-マイクログロブリンはHLA抗原クラスⅠのL鎖で悪性リンパ腫の他、多発性骨髄腫・慢性リンパ性白血病、慢性腎不全、自己免疫性疾患でも上昇し、ほとんど診断価値はありません。
甲状腺原発悪性リンパ腫の母体となる甲状腺の病気、
- 甲状腺機能低下症/橋本病
- 甲状腺機能亢進症/バセドウ病
の甲状腺ホルモン値を反映する事が多いです。しかし、急激に増大する時は、
- 破壊性甲状腺炎(甲状腺中毒症)
- 急速な甲状腺機能低下症
になります。
血清サイログロブリンが上昇。甲状腺良性腫瘍(腺腫様甲状腺腫、良性濾胞腺腫)、甲状腺分化癌(甲状腺濾胞癌、甲状腺乳頭癌)、甲状腺低分化がん など、腫瘍が産生するサイログロブリンでなく、甲状腺組織の破壊による上昇です(破壊性甲状腺炎と言ってもよいでしょう)。抗サイログロブリン抗体(Tg-Ab)陽性なら、実際よりも低い値になります(抗サイログロブリン抗体(Tg-Ab)の影響でサイログロブリンが実際値より低くなる機序)。
甲状腺悪性リンパ腫が緩やかに大きくなる場合、サイログロブリン値は数百ng/mLに、急激に大きくなる場合、数千ng/mLになる事も。報告例では、
- 血清サイログロブリン 2,170 ng/mL (第61回 日本甲状腺学会 O22-4 橋本病の長期経過中に甲状腺が急速に腫大し、コア生検で診断し得た甲状腺MALTリンパ腫の一例)
- 抗サイログロブリン抗体(Tg-Ab)存在下で血清サイログロブリン 600 ng/mL [World J Surg Oncol. 2012 Apr 19;10:58.]
B細胞系リンパ腫の瀘胞性リンパ腫(FL)やびまん性大細胞型Bリンパ腫(DLBCL)はBCL2遺伝子[アポトーシス抑制遺伝子, t(14;18)(q32;q21) 転座]が特徴的に認められます。
MYC 転座は、全びまん性大細胞型Bリンパ腫(DLBCL)の5~15%に認められ、R-CHOP療法に治療抵抗性で予後不良とされます。[Diagn Cytopathol. 2022 Feb;50(2):84-85.]
しかし、MYC 転座陽性甲状腺びまん性大細胞型Bリンパ腫(DLBCL)がR-CHOP療法に良く反応した報告もあります。(第59回 日本甲状腺学会 P3-4-4 破壊性甲状腺炎をともなったMYC 転座陽性甲状腺悪性リンパ腫の1 例)
甲状腺原発悪性リンパ腫は、甲状腺濾胞癌とは逆に、中心部になる程、細胞密度が高い。よって、中心部(右の円の中)から細胞を採ると以下のようになります。
甲状腺原発悪性リンパ腫の細胞像は、
- 単一(モノトーナス、モノクローナル)な腫瘍細胞が多数
- 孤立性散在性、細胞集団を形成しない
- 核はMALTリンパ腫(中型)、びまん性大細胞型Bリンパ腫(DLBCL)(大型)ともにN/C比(核/細胞質比)が大で細胞質が乏しい
- びまん性大細胞型Bリンパ腫(DLBCL)では、クロマチンは淡く染まり、核小体は明瞭・非腫瘍性の小型リンパ球とtwo cell patternになる
- 背景は汚く、貪食細胞が出現することも
(写真;バーチャル臨床甲状腺カレッジより)
甲状腺悪性リンパ腫の診断。特に異型性の少ないMALTリンパ腫はsIL2-R正常、穿刺細胞診にて診断不可能なのでガリウムシンチグラフィーが有用。甲状腺乳頭癌・甲状腺濾胞癌にはほとんど集積せず、甲状腺未分化癌にも強く集積。組織生検(コア生検)・オープン バイオプシー・手術標本で確定診断。気道閉塞の危険があればステロイド大量投与(ステロイドパルスなど)で劇的に縮小して治療的診断に。PET-FDGは橋本病(慢性甲状腺)でも結節状に取り込み(集積)、最大集積値(SUVmax)も同程度で診断に有用性ないが、確定診断後の進行度分類[Ann Arbor分類]に必要。
甲状腺悪性リンパ腫,診断,ガリウムシンチグラフィー,組織生検,集積,治療的診断,PET-FDG/CT,最大集積値,SUVmax,確定診断
甲状腺悪性リンパ腫は、腫瘍マーカーであるsIL2-R(可溶性インターロイキン2受容体)正常で、穿刺細胞診でも診断不可能なことが多々あります(特にMALTリンパ腫)。
穿刺細胞診の感度40-50%。[MALTリンパ腫のほとんどは、良性(クラス2)かグレ-ゾーン(クラス3)となり、明らかに癌と診断できるクラス4,5は稀です]。[Eur J Endocrinol. 2019 Mar;180(3):177-187.][MALTリンパ腫、びまん性大細胞型Bリンパ腫(DLBCL)の穿刺細胞診の所見は、前項 を御覧ください。]
このような場合、
- ガリウムシンチグラフィー(67Gaシンチグラフィー)が有用。強い集積があれば、甲状腺悪性リンパ腫の疑い濃厚 [Ann Nucl Med. 2003 Jul;17(5):351-7.]
ただし、超音波(エコー)検査で明らかな甲状腺悪性リンパ腫なら、ガリウムシンチグラフィーは省略できます
- 甲状腺組織生検[組織診、コア生検(core needle biopsy:CNB)]で確定診断[感度(90.9%)]を内分泌外科に依頼します[Langenbecks Arch Surg. 2023 May 24;408(1):206.]。免疫組織化学を併用すれば診断精度100%[Diagn Cytopathol. 2020 Nov;48(11):1041-1047.]。
※悪性リンパ腫は非常に多くの病理組織型に分類されるため、正確な組織型の分類(subtype)と適切な治療方針決定を行うには、十分な量の組織検体が必要。甲状腺組織生検[組織診、コア生検(CNB)]でも検体量が不足することが多く、ある程度の診断しか付かない。
- それでも確定診断に至らない場合、外科的生検(「造血器腫瘍診療ガイドライン 」でも推奨)
①全身麻酔下にopen biopsy(オープン バイオプシー;切開して組織を一部取り出す)を施行すれば確定診断できます[Surg Oncol. 2010 Dec;19(4):e124-9.][Langenbecks Arch Surg. 2023 May 24;408(1):206.]。
②しかし、明らかな甲状腺悪性リンパ腫か、あるいはすぐに切除せねばならない状態(周囲組織へ浸潤、気管等圧排)であれば、(open biopsyせずに)甲状腺を手術摘出し、手術標本の病理診断で確定する事もよくあります。[Langenbecks Arch Surg. 2023 May 24;408(1):206.](第55回 日本甲状腺学会 P2-05-02 バセドウ病に甲状腺原発悪性リンパ腫を合併した1 例)
最近では、甲状腺内視鏡手術の普及により、甲状腺手術のハードルが下がり(全身麻酔、1週間の入院は必要だが)、内視鏡的試験切除手術で診断するケースも増えています。これなら、診断率は100%です。筆者が提携している甲状腺外科の先生も、甲状腺組織生検[組織診、コア生検(CNB)]をする位なら、リスクと診断率を考えて内視鏡的試験切除手術を選択されます。ただし、甲状腺半葉切除となるので、術後甲状腺機能低下症を避けられず、生涯、甲状腺ホルモン剤(チラーヂンS)服薬が必要となる可能性があります。
気道閉塞の危険があれば、ステロイド大量投与(ステロイドパルスなど)による治療的診断(下記)。
ガリウムシンチグラフィー(67Gaシンチグラフィー)は甲状腺悪性リンパ腫の診断において非常に有用です。[Ann Nucl Med. 2003 Jul;17(5):351-7.]
- 甲状腺乳頭癌・甲状腺濾胞癌にはほとんど集積しない
- 甲状腺悪性リンパ腫、甲状腺未分化癌に強く集積する
- 同時に、甲状腺悪性リンパ腫、甲状腺未分化癌の全身転移検索(病期判定)に有効
- 治療後のフォローアップに有用
PET-FDG/CTは甲状腺悪性リンパ腫の
- 診断に有用ではありません。
背景にある橋本病(慢性甲状腺)の約30%は結節状(nodular)に集積し、甲状腺悪性リンパ腫と鑑別できません。
同時に、アイソトープ(18-FDG)の最大集積値(SUVmax)も甲状腺悪性リンパ腫と橋本病(慢性甲状腺)で有意差なく、背景にある橋本病(慢性甲状腺)の、びまん性集積が甲状腺悪性リンパ腫をマスクします。
(第53回 日本甲状腺学会 P-128 甲状腺悪性リンパ腫の病期診断における FDG PET の意義)
ただし、びまん性大細胞型B細胞リンパ腫(DLBCL)に限定すれば有用な可能性があります[Clin Nucl Med. 2013 Sep;38(9):709-14.]
- 確定診断が付いた後は、悪性リンパ腫病期(進行度)分類[Ann Arbor分類]を行うのに必要です。
その際、耳下腺炎、大腸腺腫、原発性肺がんなどでPET-FDG/CTが陽性になり、病期(進行度)分類を間違える可能性があります。
甲状腺悪性リンパ腫の治療効果判定にも有用。
[Acta Radiol. 2009 Mar;50(2):201-4.][下、写真 Indian J Nucl Med. 2022 Oct-Dec;37(4):379-386.より改変]
気管圧迫症状が出現し、気道閉塞の危険があれば、とりあえず緊急入院後、ステロイド大量投与(ステロイドパルスなど)による治療的診断を行う。甲状腺悪性リンパ腫なら劇的に縮小します。危機を脱したら、穿刺細胞診、組織生検、ガリウムシンチグラフィー(67Gaシンチグラフィー)で確定診断。
穿刺細胞診では診断不可能な事がほとんどです。甲状腺悪性リンパ腫の腫瘍マーカーsIL2-R(可溶性インターロイキン2受容体)も正常な事が多く、例え上昇しても軽度です。このような場合、甲状腺悪性リンパ腫の診断に記載されてる通り、
- ガリウムシンチグラフィー(67Gaシンチグラフィー)
- 穿刺細胞診より一段階上の甲状腺組織生検[組織診、コア生検(core needle biopsy:CNB)]
- 全身麻酔下にopen biopsy(オープン バイオプシー)
- 内視鏡的試験切除手術、甲状腺の手術摘出
を施行します。
紫の点が悪性リンパ腫細胞の核です。甲状腺濾胞に浸潤しているのが解ります。MALT ballと呼ばれるものですが、MALT ballがあるからと言って悪性リンパ腫とは限りません。群馬パース大学 保健科学部 蒲 貞行先生によるとMALT ball内部は「小型~中型の細胞ながら、核小体の長径が核長径の1/4以上、すなわち [核小体/核]-比 が1/4以上で、不整形の核を持つ腫瘍細胞」とされます(リンパ球系病変の純細胞形態学的観察法)
すなわち、甲状腺濾胞に浸潤しているリンパ球系細胞があるからと言って悪性リンパ腫細胞とは限りません。炎症性にリンパ球が甲状腺濾胞に浸潤している病態は、intraepithelial lymphocytosisと呼ばれ、バセドウ病や橋本病(慢性甲状腺炎)でも認められます
[Activated interstitial and intraepithelial thyroid lymphocytes in autoimmune thyroid disease. Acta Endocrinol (Copenh). 1988 Oct;119(2):161-6.]
[Predominant intraepithelial localization of primed T cells and immunoglobulin-producing lymphocytes in Graves' disease. Acta Endocrinol (Copenh). 1991 Jun;124(6):630-6.]
[Immunohistochemical characterization of intrathyroid lymphocytes in Graves' disease. Interstitial and intraepithelial populations. Am J Med. 1984 May;76(5):815-21.]。
リーデル甲状腺炎によるintraepithelial lymphocytosis
riedels-thyroiditis-residual-atrophic-follicle-fibrosis(Medbullets Team)
頚部リンパ節に悪性リンパ腫が発生し、橋本病やバセドウ病を伴う場合、甲状腺原発か甲状腺外か鑑別しにくいことが多々あります。
頚部リンパ節原発のホジキンリンパ腫が、甲状腺に浸潤した症例が報告されています。(第54回 日本甲状腺学会 P246 急速なびまん性甲状腺腫大の1例-Hodgkinリンパ腫の甲状腺病変)
を御覧ください。
確かに、発熱、頚部の痛み、急激な甲状腺の腫れ等、症状は共通するものの、超音波(エコー)所見が全く異なるため、まさか甲状腺原発悪性リンパ腫を亜急性甲状腺炎と間違える事はないだろうと筆者は考えておりました。
しかし、恐ろしいことに、「発熱、頚部の痛み」の2点がそろい、血液検査で炎症反応を認めると、亜急性甲状腺炎と決め付けて、ためらうことなくステロイド剤を開始する内科医が異常に多いのです。甲状腺部に痛みを呈する疾患の74.1%は亜急性甲状腺炎ですが、残りの約25%は他の病気です(甲状腺の痛み)。
甲状腺専門医は、超音波(エコー)検査なしで亜急性甲状腺炎の診断をする事はありません。
(Acta Cytol. 2006 Nov-Dec;50(6):710-2.)(Harefuah. 1987 Mar 1;112(5):226-7.)
甲状腺原発悪性リンパ腫のように見えても、「実は無痛性甲状腺炎の炎症巣だった」という場合もあります。穿刺細胞診を行えば、炎症性のリンパ球を多数認めます。細胞異型は無く、モノクローナルな増殖で無いため、炎症性リンパ球浸潤と診断できます。無痛性甲状腺炎であるため、数か月で低エコー領域は消失します、
甲状腺未分化癌との速やかな鑑別が必要
甲状腺未分化癌との速やかな鑑別が必要。甲状腺原発悪性リンパ腫ならCHOP療法などの化学療法行えば、速やかな腫瘍縮小と気道閉塞解除が期待できます。しかし、甲状腺未分化癌との鑑別が、意外と難しい事があります。微細~破片状石灰化などを伴う典型的な甲状腺乳頭癌成分が存在していれば、超音波(エコー)所見だけでも甲状腺未分化癌と判ります。そうでない場合、甲状腺の穿刺細胞診しても、
- 甲状腺原発悪性リンパ腫細胞は異型性が少なく病理診断が難しい
- 甲状腺未分化癌は壊死組織が多く、その部分を採取しても細胞が採れない。
次に、甲状腺針生検(組織診)か、血液内科の力を借りて穿刺細胞診材料でフローサイトメトリー(リンパ球の細胞表面抗原を特定)行うかですが、
- 針生検(組織診)は侵襲大きいため、気道閉塞し掛けた状態では行い難い。
- フローサイトメトリーは頼めば迅速に動いてくれる血液内科が必要
(第54回 日本甲状腺学会 P245 甲状腺未分化癌との鑑別に苦慮した甲状腺悪性リンパ腫の一例)
(第54回 日本甲状腺学会 P248 細胞診による迅速診断と化学療法で窒息を回避できた甲状腺悪性リンパ腫の一例)
橋本病の破壊(変性)が強い場所は低エコー(黒い)で、悪性リンパ腫と鑑別する必要があります。橋本病反応性リンパ球浸潤のようにリンパ球が集簇して炎症の強い状態でなく、すでに炎症のピークは過ぎて、破壊されてしまった状態[結節性橋本病(橋本病結節)に近い病変]なので、穿刺細胞診により鑑別できます。
甲状腺関連の上記以外の検査・治療 長崎甲状腺クリニック(大阪)
長崎甲状腺クリニック(大阪)とは
長崎甲状腺クリニック(大阪)は日本甲状腺学会認定 甲状腺専門医[橋本病,バセドウ病,甲状腺超音波(エコー)検査など]による甲状腺専門クリニック。大阪府大阪市東住吉区にあります。平野区,住吉区,阿倍野区,住之江区,松原市,堺市,羽曳野市,八尾市,東大阪市,浪速区,天王寺区,生野区も近く。